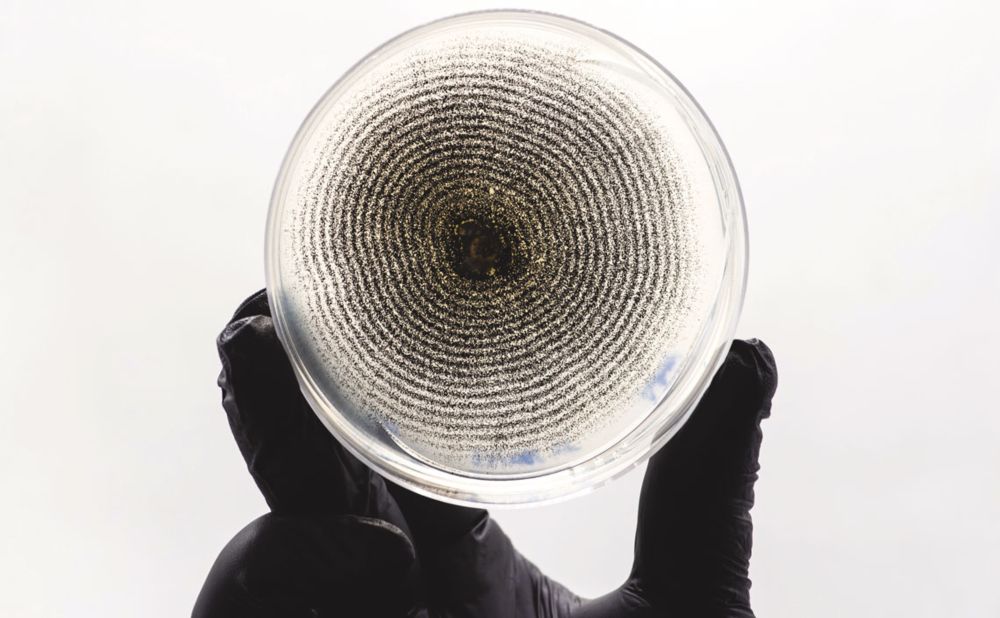

de vdd sou tímida, muito tímida

youtu.be/1SaLVf2gz-s?...

youtu.be/1SaLVf2gz-s?...
—
🔄 Em atualização

—
🔄 Em atualização
Por Plínio Teodoro
Investigações da PF avançam sobre conexão drogas, armas, combustíveis, Faria Lima e políticos que fazem lobby para bancos e armas.

Por Plínio Teodoro
Investigações da PF avançam sobre conexão drogas, armas, combustíveis, Faria Lima e políticos que fazem lobby para bancos e armas.
noticias.uol.com.br/politica/ult...
noticias.uol.com.br/politica/ult...
O Feminismo incomoda mais que o feminicídio porque eles se incomodam mais com a mulher livre do que a mulher morta. 🤨
O Feminismo incomoda mais que o feminicídio porque eles se incomodam mais com a mulher livre do que a mulher morta. 🤨
Cientistas de mais de dez países assinaram, com a China, um compromisso de cooperação internacional para atingir o “plasma em ignição”, que pode revolucionar a produção mundial de energia.
#Resistencia2709Dias

Cientistas de mais de dez países assinaram, com a China, um compromisso de cooperação internacional para atingir o “plasma em ignição”, que pode revolucionar a produção mundial de energia.
#Resistencia2709Dias
A CCJ aprovou a revogação da Lei de Alienação Parental, usada de forma injusta contra mulheres e crianças.
Quando denunciar abuso vira risco de perder a guarda, o Estado falha.
Proteger a infância é prioridade absoluta. 💛
A CCJ aprovou a revogação da Lei de Alienação Parental, usada de forma injusta contra mulheres e crianças.
Quando denunciar abuso vira risco de perder a guarda, o Estado falha.
Proteger a infância é prioridade absoluta. 💛
agen.pub/mklabintl

agen.pub/mklabintl
'Sirat', 'A Poet', 'On Becoming a Guinea Fowl' e 'All That's Left of You' também concorrem.




'Sirat', 'A Poet', 'On Becoming a Guinea Fowl' e 'All That's Left of You' também concorrem.



Centros de pesquisa e empresas oferecem ao campo bioinsumos que combatem pragas e até protegem contra a seca. Ao rivalizarem com agroquímicos, retiram veneno da água e alimentos – e economizam bilhões. E o grande condutor é o investimento público
Centros de pesquisa e empresas oferecem ao campo bioinsumos que combatem pragas e até protegem contra a seca. Ao rivalizarem com agroquímicos, retiram veneno da água e alimentos – e economizam bilhões. E o grande condutor é o investimento público

*** DIA 07/12 NO BRASIL TODO ***
Rio de Janeiro: Copacabana Posto 5 às 10h
São Paulo: Concentração no MASP às 12h para início às 14h.
RT POR FAVOR!

*** DIA 07/12 NO BRASIL TODO ***
Rio de Janeiro: Copacabana Posto 5 às 10h
São Paulo: Concentração no MASP às 12h para início às 14h.
RT POR FAVOR!
Bacellar (União Brasil-RJ), bolsonarista presidente da Alerj, é preso por elo com TH Joias, que vendia armas ao CV
revistaforum.com.br/politica/202...
Rodrigo Bacellar, presidente da Alerj, foi preso pela PF por vazar informações sobre a operação que levou TH Joias,...
1/2⤵️

Bacellar (União Brasil-RJ), bolsonarista presidente da Alerj, é preso por elo com TH Joias, que vendia armas ao CV
revistaforum.com.br/politica/202...
Rodrigo Bacellar, presidente da Alerj, foi preso pela PF por vazar informações sobre a operação que levou TH Joias,...
1/2⤵️





